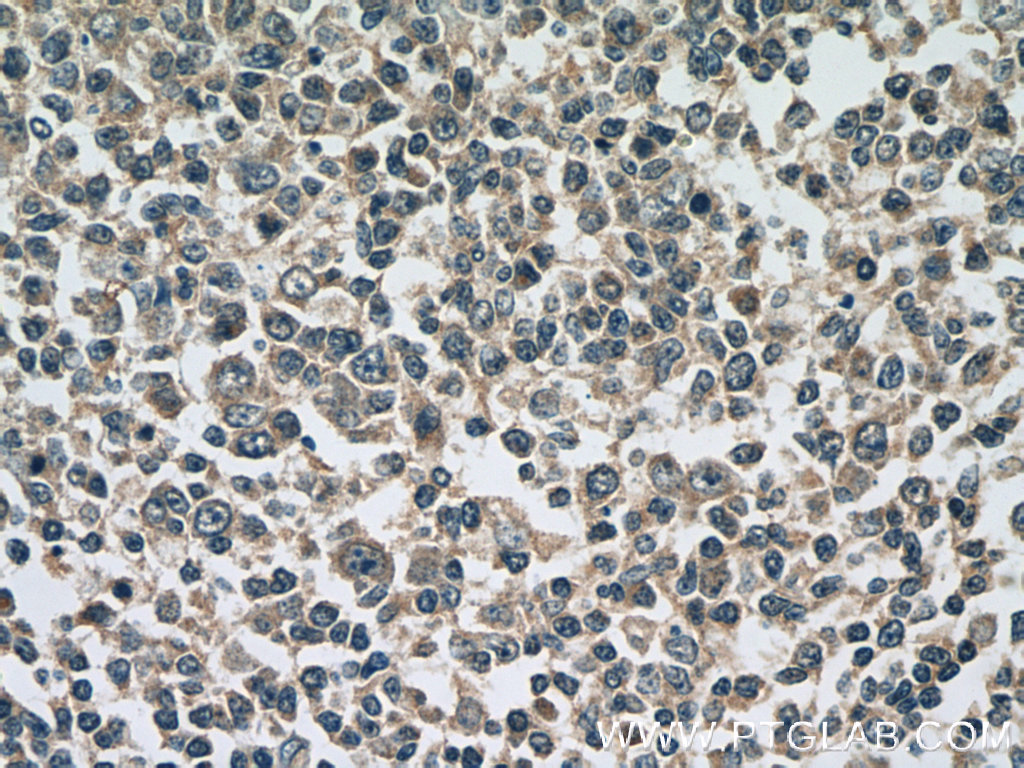
ATG2A Polyclonal antibody

ATG2A Polyclonal antibody
ATG2A Polyclonal antibody
Storage Temperature: Store at -20°C. Stable for one year after shipment.
Species: human
Host: Rabbit
Application: WB, IHC, IF,ELISA
GeneID: 23130
Size: 150
UL
Internal Reference:
23226-1-AP-150UL
ATG2A Polyclonal antibody Storage Temperature: Store at -20°C. Stable for one year after shipment. Species: human Host: Rabbit Application: WB, IHC, IF,ELISA GeneID: 23130 Size: 150 UL